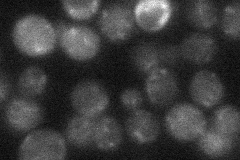
YJR040W
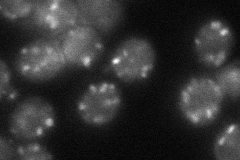
YJR040W
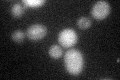
YJR040W
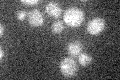
YJR040W

View description
Voltage-gated chloride channel localized to the golgi, the endosomal system, and plasma membrane, and involved in cation homeostasis; highly homologous to vertebrate voltage-gated chloride channels
Localization:
Intensity:
Fold change:
Significance:
-
C’ GFP library in SD

below threshold16.09 -
N' NOP1pr-GFP in SD

punctate87.4835 -
N' TEF2pr-mCherry in SD

punctate112.608 -
N' NATIVEpr-GFP in SD
below threshold22.4799 -
N' TEF2pr-VC and Cyto-VN in SD
punctate47.4956 -
C’ GFP library in SD+DTT
cytosol16.281.01No -
C’ GFP library in SD+H2O2

cytosol14.640.9No -
C’ GFP library in Starvation Media
cytosol16.581.03No -
C’ GFP library on the background of Pup2-DaMP

below threshold -
C’ GFP library on the background of CCT mutant

below threshold15.66940.973313No
